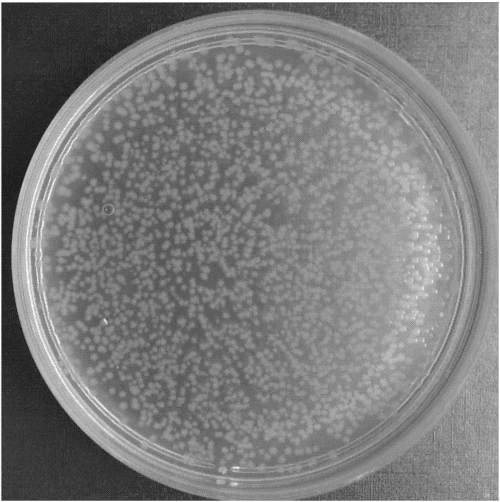

解脂耶氏酵母(Yarrowia Iipolytica),属于子囊酵母,是被广泛研究的非常规菌种之一。该菌株安全、无毒,既能在海水中也能在淡水中生存。可以以葡萄糖、乙醇、乙酸和脂肪酸、烃类等物质为碳源进行生长,通常用于有机废水的处理或者油脂的富集。
实验工艺
微思细胞破碎仪高压低温破壁五遍
实验目的
破碎率>90%
实验结果
A. 外观
破壁后的解脂耶氏酵母样品浓度变高,表面浮有一层细胞残渣。

B. 显微镜观察
显微镜观察结果,解脂耶氏酵母破壁率超90%。

初始

破壁后